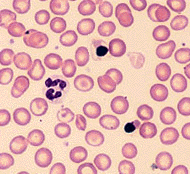

تلاسيميا
Thalassemia | |
---|---|
الأسماء الأخرى | Thalassaemia, Mediterranean anemia |
![]() | |
Peripheral blood film from a person with Delta Beta thalassemia | |
النطق | |
التخصص | Hematology |
الأعراض | Feeling tired, pale skin, enlarged spleen, yellowish skin, dark urine[1] |
المسببات | Genetic disorders (inherited)[2] |
الطريقة التشخيصية | Blood tests, genetic tests[3] |
العلاج | Blood transfusions, iron chelation, folic acid[4] |
التردد | 280 million (2015)[5] |
الوفيات | 16,800 (2015)[6] |
مرض الثلاسيميا Thalassemia من أهم أمراض الدم الوراثية الانحلالية- التي تسبب تكسر كريات الدم الحمراء- الشائعة على مستوى العالم بشكل عام وعلى مستوى منطقة البحر الأبيض المتوسط بشكل خاص ، و الثلاسيميا نوعان الألفا و البيتا وحين يأتي الحديث عن هذا المرض فإننا نقصد به (البيتا ثلاسيميا ).

والثلاسيميا كلمه يونانية الأصل تعني فقر دم منطقة البحر الأبيض المتوسط حيث أن هذا المرض عرف واشتهر في هذه المنطقة بشكل كبير و ، ويعرف أيضا باسم أنيميا البحر المتوسط (Mediterranean anemia) وفي الولايات المتحدة الأمريكية كان يعرف باسم أنيميا كوليز (Cooleys anemia).وفي منطقة البحر الأبيض المتوسط كان لا بد أن يخضع كل مولود جديد بعد ولادته بشهور لهذا الفحص لمعرفة ما إذا كان حاملا أو مصابا بالبيتا ثلاسيميا .أما في منطقة الخليج العربي يحمل كل فرد من بين 20 فرد لهذا المرض أي نسبه حاملي صفة المرض في الخليج 5 % وهي نسبه لا يمكن تجاهلها حيث أنه في كل مرة تحمل فيه امرأة حاملة للمرض ومتزوجة من رجل أيضا حامل للمرض فإن احتمال إصابة الجنين تصل إلى 25% وان اكثر من 60% من أطفال هذه الأسرة السليمين أيضاً حاملين للمرض. وتكمن مشكلة المرض في عدم قدرة الجسم من تكوين كريات الدم الحمراء - التي تنقل الغذاء والأكسجين إلى مختلف أنحاء الجسم – بشكل سليم نتيجة لخلل في تكوين الهيموجلوبين( خضاب الدم) أدى إلا عدم اكتمال نضج الكريه الحمراء و تكسرها وتحللها بعد فتره قصيرة من إنتاجها (يذكر أن عمر كريه الدم الحمراء تكون 120 يوما) لذ فان المريض يحتاج إلى نقل دم بشكل دوري كل 3-4 أسابيع حسب عمره و درجه نقص الهيموجلوبين .
ينتشر المرض في عدة مناطق من العالم ولكنها تكثر في المناطق التالية:
- حوض البحر الأبيض المتوسط ( اليونان، مالطا، قبرص، تركيا و إيطاليا).
- منطقة الخليج العربي.
- منطقة الشرق الأوسط وتشمل إيران العراق سوريا الأردن وفلسطين.
- شمال أفريقيا وتشمل مصر تونس الجزائر المغرب وبعض من الدول الأفريقية الأخرى.
- جنوب شرق أسيا وتشمل تايلاند، الفلبين، إندونيسيا، سنغافورة، كمبوديا، فيتنام وماليزيا.
- شبه القارة الهندية.
- دول أخرى كالصين، أرمينيا، جورجيا، أذربيجان.
انواع الثلاسيما
علاج الثلاسيميا
مريض التلاسيميا يحتاج إلى نقل متكرر للدم (من 3 إلى أربع أسابيع) وطوال عمر المريض ينتج عن تكرار نقل الدم مشاكل كثيرة أهمها:
- زيادة نسبة الحديد في الجسم
- هشاشة في العظام
- ضعف عام في الجسم
- تأخر البلوغ
لايوجد حاليا اي علاج للثلاسيما غير زراعة نخاع العظم.
وصلات خارجية
- Errant Gene Therapeutics - Caring for Orphan Diseases: Thalagen - Gene therapy treatment for beta Thalassemia
- Mendelian Inheritance in Man (OMIM) 141900 (beta-thalassemia), Mendelian Inheritance in Man (OMIM) 141800 (alpha-thalassemia)
- Cooley's Anemia Foundation Leading the fight against thalassemia
- Northern Comprehensive Thalassemia Center: Provides information about the disease and related matters.
- Thalassemia Free Pakistan, A private charity foundation providing research material, and support for thalassemic patients and their families
- Thalassemia Overview (Latest Research)
- Thalassemia Patients and Friends: Message board for those affected.
- Thalforum.com - Thalassemia Community Forum: Thalassemia Discussion Forum for Thalassemia Patients, Families and Care-givers.
- Thalassemia Foundation of Canada:
- Hemoglobal A fully registered Canadian charity providing medical aid to Sri Lankan children with thalassemia.
- Thalassemia Support Foundation Helping Patients Find Hope
- Micrel Medical Devices Sells Iron-Chelation equipment for Thalassemia patients
- Thalassaemia in India Thalassaemia in India
مصادر
![]() |
هذه بذرة مقالة عن العلوم الطبية تحتاج للنمو والتحسين، فساهم في إثرائها بالمشاركة في تحريرها. |
- ^ خطأ استشهاد: وسم
<ref>
غير صحيح؛ لا نص تم توفيره للمراجع المسماةNIH2012Sym
- ^ خطأ استشهاد: وسم
<ref>
غير صحيح؛ لا نص تم توفيره للمراجع المسماةNIH2012Cau
- ^ خطأ استشهاد: وسم
<ref>
غير صحيح؛ لا نص تم توفيره للمراجع المسماةNIH2012Diag
- ^ خطأ استشهاد: وسم
<ref>
غير صحيح؛ لا نص تم توفيره للمراجع المسماةNIH2012Tx
- ^ GBD 2015 Disease and Injury Incidence and Prevalence, Collaborators. (8 October 2016). "Global, regional, and national incidence, prevalence, and years lived with disability for 310 diseases and injuries, 1990-2015: a systematic analysis for the Global Burden of Disease Study 2015". Lancet. 388 (10053): 1545–1602. doi:10.1016/S0140-6736(16)31678-6. PMC 5055577. PMID 27733282.
{{cite journal}}
:|first1=
has generic name (help)CS1 maint: numeric names: authors list (link) - ^ خطأ استشهاد: وسم
<ref>
غير صحيح؛ لا نص تم توفيره للمراجع المسماةGBD2015De